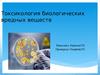
Токсикология биологических вредных веществ

Similar presentations:
Биотехнология как источник био-риска
1. БИОТЕХНОЛОГИЯ КАК ИСТОЧНИК БИО-РИСКА
БИОТЕХНОЛОГИЯ КАК ИСТОЧНИК БИОРИСКА• Этапы развития биотехнологии и их характеристика
• Сферы применения биотехнологии
• Биобезопасность. Основные термины и концепции
биобезопасности.
• Сущность биотехнологического риска и его классификация
2. Биотехнология
Трансдисциплинарная область знания, которая наоснове теорий и методов микробиологии, биохимии,
генетики, иммунологии, химической технологии,
приборо- и машиностроения разрабатывает
рациональные схемы использования биологических
объектов для промышленного производства веществ
и продуктов (по определению Европейской
биотехнологической федерации).
3. Биологические объекты
одноклеточные и субклеточные единицы (в том числе генетически модифицированные), культивируемые клетки тканейрастений и животных, способные к самовоспроизведению
4. Этапы развития биотехнологии
I. Неолитическая революция 15 -6 тыс лет до н.эII. Эмпирический период 6 тыс лет до н.э. – 19 в.н.э
III. Этиологический период 1860 - 1940 гг.
IV. Технологический период 1940 – 1970 гг
V. Генноинженерный (геннотехнический) с конца 1975 гг.
5. . Области применения продуктов и процессов биотехнологии
Медицина и фармацевтика• Антибиотики (более 100 видов), микробные
лекарственные препараты, ферменты желудочно-кишечного тракта (протеиназы и др.), витамины (В12, В2, Р-каротин, рибофлавин), полисахариды (декстран, липополисахариды, хитин
и др.), спирты (этанол), органические кислоты
(лимонная, фумаровая, молочная, глюконовая и
др.), пробиотики, вакцины, хитозан, процессы
биотрансформации при получении стероидных
гормонов, поли-р-оксибутират, биологически
активные добавки
6.
• РастениеводствоЭнтомопатогенные препараты, бактериальные
удобрения, органические кислоты (пропионовая), антибиотики, гербициды и др.
7.
• Животноводство и ветеринарияАнтибиотики (биовиты, бацитрацин и др., более
100 видов), витамины (В12, В2, D2, Р-каротин),
органические кислоты (пропионовая), ферменты (протосубтилин), белково-витаминные концентраты, пробиотики, аминокислоты, вакцины,
глобулины, биостимуляторы
8.
• Пищевая промышленностьАнтибиотики (субтилин, низин), витамины
(Р-каротин), аминокислоты (лизин, глутаминовая
кислота), ферменты (амилаза, инвертаза, лактаза
и др.), органические кислоты (лимонная, фумаровая, глюконовая, молочная и др.), биомасса
высших грибов, биологически активные добавк
9.
• Текстильная и кожевенная промышленностьФерменты (липазы, протеазы и др.), органические кислоты (лимонная, фумаровая и др.)
• Нефтяная и газодобывающая промышленность
Полисахариды (ксантан и др.), поверхностноактивные вещества
• Металлургическая промышленность
Полисахариды, липиды (фосфолипиды, триацилглицериды)
10.
• Химическая промышленностьБиотрасформация отдельных этапов в химических процессах, например,
при получении аскорбиновой кислоты, кортикостероидов, акриламида
из акрилонитрила и т.п.
• ЭКОЛОГИЯ
Биопрепараты для биоремедиации загрязненных почв, поверхностных вод и техногенных
потоков, для биокомпостирования органических отходов, очистки сточных вод и газовоздушных выбросов
11. Основной источник биотехнологического риска
• Эмиссия «биологического фактора» во внешнюю среду впроцессе реализации биотехнологических схем, т.е.
биоаэрозолей и сточных вод, содержащих живые и
инактивированные клетки, организмы, а также продукты их
синтеза и метаболизма, прежде всего, носителей чужеродной
генетической информации.
12. Методологические концепции биобезопасности
• Узкая методология определения биобезопасности - обеспечениепротивоэпидемического режима работы с возбудителями особо
опасных инфекционных болезней, и любыми патогенными
биологическими агентами, продуцируемыми в результате
биотехнологических производственных процессов.
• Широкая методология определения биобезопасности –
предотвращение любых неблагоприятных последствий
использования биотехнологий, включая социальные и
гуманитарные риски. Смена методологии, была связана с розтом
значения сер биозащиты и, впоследствии, с расширением самой
трактовки категории биориск
13. БИОЛОГИЧЕСКАЯ ОПАСНОСТЬ
• Потенциальная возможность воздействия опасных биологическихфакторов на человека, среду обитания, включая животных и
растения, результатом которого может быть возникновение
опасной биологической ситуации и перерастание ее в
чрезвычайную ситуацию биологического характера
14. БИОЛОГИЧЕСКАЯ БЕЗОПАСНОСТЬ
• Состояние защищенности населения, личности, общества,государства от прямого и/или опосредованного через среду
обитания (производственная, социально-экономическая,
геополитическая инфраструктура, экологическая система)
воздействия опасных биологических факторов
15. Предмет и основная задача БИОБЕЗОПАСНОСТИ
• Исключение перехода биотехнологического риска в актуальнуюформу (реализации риска) , т.е. снижение возможности
неблагоприятного воздействия «биологического фактора» на
здоровье человека и качество окружающей среды как на стадиях
разработки технологии, проектирования предприятий, так и на
стадиях их эксплуатации.
16. Типы БИОЛОГИЧЕСКОЙ БЕЗОПАСНОСТИ
• БИОБЕЗОПАСНОСТЬ, BIOSAFESITY - обеспечение безопасностибиотехнологии для здоровья человека, персонала, защиту от
патогенов и других вредных воздействий «биологического
фактора», как побочного результата биотехнологических
производств.
• БИОЗАЩИТА, BIOSECURITY - защита от злонамеренного
использования «биологического фактора».
17. Опасные биологические факторы
• Болезнетворные организмы любого вида, расы, биологическоготипа и токсические субстанции (микроорганизмы, представители
фауны, флоры, контаминированные объекты живой и неживой
природы, экопатогены, эпизоотический, эпидемический процесс,
эпифитотии), отсутствующие или ограниченно распространенные
на контролируемой территории, которые способны нанести вред
здоровью человека, сельскохозяйственным животным и
продукции животноводства, растениям или продукции
растительного происхождения
18. Обеспечение биологической безопасности
• Поддержание биологической безопасности на уровнеминимально приемлемого и допустимого риска воздействия
опасных биологических факторов на здоровье человека и среду
обитания при перманентных мерах по снижению минимально
приемлемого уровня риска
19. Патогенные биологические агенты
• Микроорганизмы (бактерии, вирусы, хламидии, риккетсии,простейшие, грибы, микоплазмы), прионы, генно-инженерномодифицированные организмы, яды биологического
происхождения (токсины), гельминты, способные при попадании
(введении) в организм человека или животного вызвать
инфекционное состояние (болезнь, носительство, отравление),
дифференцированные по уровням опасности и требующие
обеспечения адекватного уровня безопасности при проведении
диагностической, производственной и экспериментальной
работы
20. Негативное воздействие опасных биологических факторов
• Воздействие опасных биологических факторов на человека, создающее либонепосредственную угрозу жизни или здоровью человека, либо угрозу жизни или
здоровью будущих поколений, либо опосредованное воздействие на
жизнедеятельность человека через среду обитания
• ПРЯМОЕ ДЕЙСТВИЕ ОПАСНЫХ БИОЛОГИЧЕСКИХ ФАКТОРОВ
Действие патогенных биологических агентов (возбудители инфекционных и
паразитарных болезней, токсины) непосредственно на организм человека, которое
может привести к возникновению болезни (носительству), токсическому поражению
• ОПОСРЕДОВАННОЕ ДЕЙСТВИЕ ОПАСНЫХ БИОЛОГИЧЕСКИХ ФАКТОРОВ
• Действие болезнетворных организмов через среду обитания, которое способно
нанести вред сельскохозяйственным животным и продукции животноводства,
растениям или продукции растительного происхождения, функционированию
экосистем и опосредованное действие на жизнедеятельность человека
21. Биологический риск
Сочетание вероятности присутствия опасных биологических факторов вчеловеческом обществе и среде обитания и вероятности и силы их прямого и
опоредованного воздействия на здоровье человека; Характеризуется
параметрами «Категории биологического риска»:
территория риска, время риска, факторы риска, контингенты риска.
КРИТЕРИЕМ БИОРИСКА ЯВЛЯЕТСЯ НАЛИЧИЕ ЧУЖЕРОДНОЙ ГЕНЕТИЧЕСКОЙ
ИНФОРМАЦИИ И (ПРЕДПОЛАГАЕМЫХ) ПРОДУКТОВ ЕЕ РЕАЛИЗАЦИИ
• Минимально приемлемый уровень биологического риска
Вероятность сочетания незначительных последствий и значительной выгоды
от факторов риска в процессе осуществления народнохозяйственной
деятельности, в связи с чем человек, группа людей, или общество готовы
пойти на этот риск в условиях имеющихся научных знаний о его величине
22.
• Риск допустимыйВероятность предупреждения перехода от незначительных
последствий для здоровья человека к значительным, т.е. от
потенциально опасной к опасной биологической ситуации в
области обеспечения биологической безопасности (массовые
болезни) при проведении мероприятий по обеспечению
биологической безопасности
• Риск недопустимый
Вероятность возникновения массовых болезней из-за позднего
проведения мероприятий по обеспечению биологической
безопасности при отсутствии гарантий предупреждения
чрезвычайных ситуаций биологического характера
23. ОПАСНАЯ БИОЛОГИЧЕСКАЯ СИТУАЦИЯ
Качественное и количественное состояние опасных биологическихфакторов среды обитания в комплексе с природными и
социальными факторами, при котором имеется допустимый или
недопустимый, но контролируемый, риск неблагоприятного
воздействия на здоровье человека и сохраняется вероятность
возникновения чрезвычайных ситуаций санитарноэпидемиологического характера и в области обеспечения
биологической безопасности
24. ПОТЕНЦИАЛЬНО ОПАСНАЯ БИОЛОГИЧЕСКАЯ СИТУАЦИЯ
• Качественное и количественное состояние опасныхбиологических факторов среды обитания в комплексе с
абиотическими ее объектами, при котором отсутствует или
имеется приемлемый риск их воздействия на здоровье человека
и возникает угроза возникновения опасной биологической
ситуации
25. ЧРЕЗВЫЧАЙНАЯ БИОЛОГИЧЕСКАЯ СИТУАЦИЯ
• Качественное и количественное состояние опасныхбиологических факторов, при котором уровень их прямого и/или
опосредованного воздействия соизмерим с угрозой
национальной и международной безопасности
26.
• ЕСТЕСТВЕННАЯ БИОЛОГИЧЕСКАЯ ОПАСНАЯ СИТУАЦИЯСитуация, определяемая негативным воздействием на здоровье
человеека вследствие естественной активизации эпидемического,
эпизоотического, эпифитотического процесса, нарушения
функционирования экосистем и вовлечения человека в
циркуляцию патогенных биологических агентов, представляющих
собой внутренние и внешние угрозы биологической безопасности
• ИСКУССТВЕННАЯ БИОЛОГИЧЕСКАЯ ОПАСНАЯ СИТУАЦИЯ
Опасная биологическая ситуация, обусловленная техногенными
авария-ми, катастрофами, связанными с неконтролируемым
выходом патогенных биологических агентов во внешнюю среду, а
также актами умышленного применения патогенных
биологических агентов в террористических и военных целях
27. АНТРОПОГЕННАЯ БИОЛОГИЧЕСКАЯ ОПАСНАЯ СИТУАЦИЯ
Опасная биологическая ситуация, возникшая в результатеантропогенного воздействия на экосистемы природных очагов в
процессе осуществления хозяйственной деятельности человека, а
также преднамеренно созданная для причинения моральнопсихологического, экономического, политического ущерба,
отличительными признаками которой являются неожиданная,
необычная, серьезная реализация категорий биологического
риска.



























 biology
biology